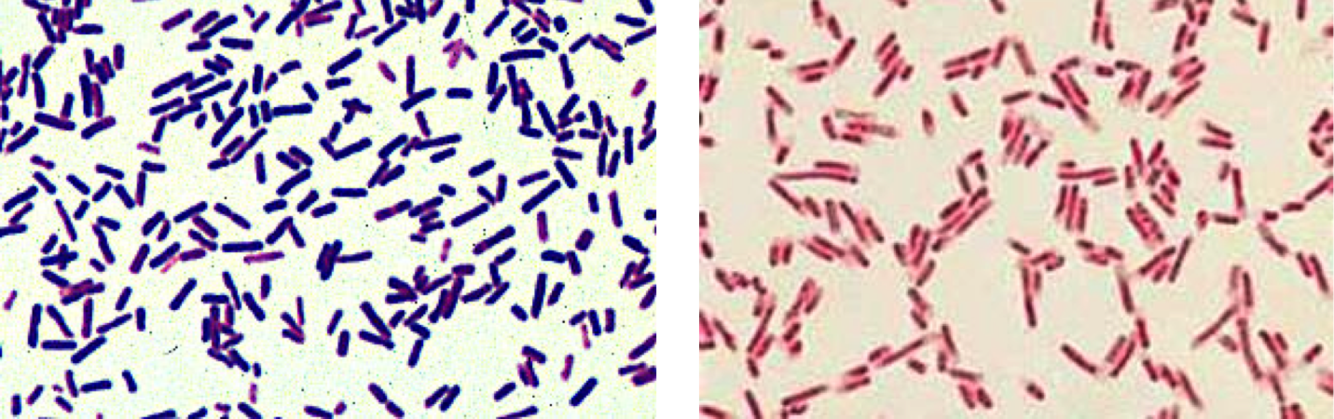
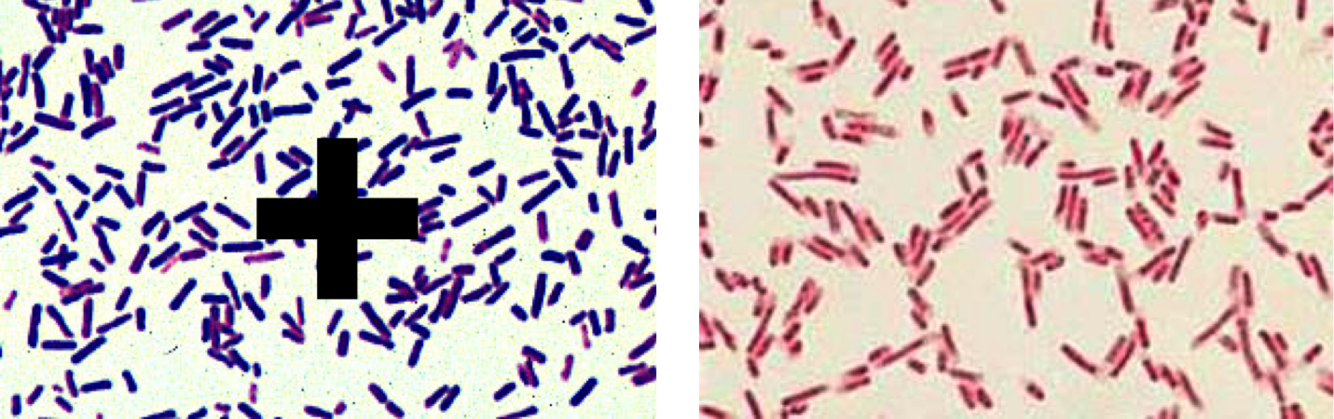

Plantae
(Chlorophyta/Green Algae)
Volvox


Plantae - plants
Chlorophyta/Green Algae
Volvox


Plantae - Plants
Volvox
(Green Algae/Chlorophyta)


Plantae - plant
(Green Algae/Chlorophyta)
Spirogyra


Stramenopila - “hairy flagella”
(Water Mold/Oomycete)
Saprolegnia
Gametes


Alveolata -“alveoli” on ther cell membranes
(Ciliates)
Paramecium


Plante
(Green Algae/Chlorophyta)
Oedogonium


Rhizaria -“root-like” pseudopods
(Foraminifera)
Forams


Excavata -“excavated” feeding groove on outside of cells
(Euglenid)
Euglena


Stramenopila -“Hairy Flagella”
(Diatoms)


Amoebozoa - move with “amoeboid” motion
(Lobose amoebae)
Amoeba


Alveolata - move with “amoeboid” motion
(Dinoflagellates)
Ceratium


Amoebozoa
(Plasmodial slime mold)
Physarum

Excavata - “excavated” feeding groove on outside of cells
(Parabasilid)
Trichonympha


Excavata: “excavated” feeding groove on outside of cells
(Euglenid)
Euglena


Plantae
(Red Algae/Rhodophyta)
Polysiphonia


Stramenopila - “hairy flagella”
(Brown Algae/Phaeophyta)
Postelsia “Sea Palm”

Stramenpolia - “hairy flagella”
(Brown Algae/Phaeophyta)
Saragassum
Compare & Contrast the Domains

Compare & Contrast Prokaryotes vs Eukaryotes
Prokaryotes
Eukaryotes
Eubacteria

Eubacteria
Give examples of Eubacteria

Gram positive bacteria
Gram negative bacteria
Cyanobacteria
Which is Gram Positive and Gram Negative
+ Thick layer of peptidoglycan
(retains crystal violet stain & looks purple)
- Thin layer of peptidoglycan
(covered by outher membrane)
What is Cyanobacteria?
Blue-green Algae
Gram negative bacteria
Photosynthetic (phycobilin pigments)
Single cells, filaments, colonies
